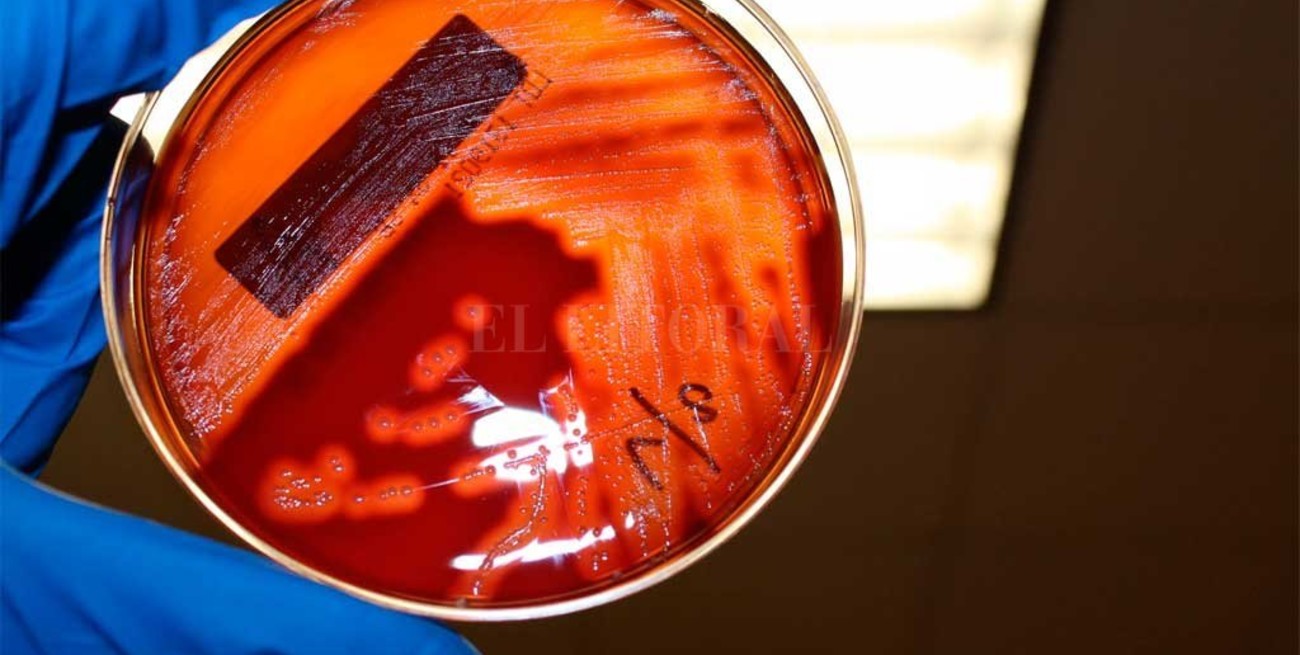
Murió un bebé y son 6 las víctimas fatales por la bacteria streptococcus pyogenes

El Litoral
Es una bacteria súper frecuente y que suele dar cuadros muy leves de faringitis o de infecciones en la piel, que muy de vez en cuando terminan en cuadros más graves.
El Litoral
Pasado el mediodía de este miércoles, se conoció que hay una nueva víctima fatal relacionada a la bacteria Streptococcus pyogenes . Un bebé de 20 meses de Viedma murió en un sanatorio privado de General Roca. El fallecimiento se produjo el 3 de septiembre, pero las autoridades sanitarias locales lo confirmaron recién ahora, destaca Clarín.
El bebé "ya tenía una patología previa, estaba con neumonía y se sobreinfectó”, informó María de las Mercedes Iberó, secretaria de relaciones Institucionales del Ministerio de Salud de Río Negro.
En tanto, este miércoles a primera hora, el Ministerio de Salud de la provincia de Buenos Aires confirmó la muerte del primer adulto por el Streptococcus pyogenes. Se trata de un hombre de 38 años oriundo de la localidad de Pergamino.
Con estas, son seis las víctimas fatales producto de esta bacteria: dos nenes en Buenos Aires, una en Rosario y otra en Misiones, destaca Clarín.
Sobre el fallecimiento del pergaminense, desde el Ministerio de Salud de la provincia de Buenos Aires informaron que presentó "neumonía con derrame pleural, que evolucionó en 48 horas a sepsis y murió".
Desde el Ministerio de Salud santafesino explicaron que se está investigando este último caso y descartaron que se trate de un brote.
“El streptococcus pyogene es una bacteria súper frecuente y que suele dar cuadros muy leves de faringitis o de infecciones en la piel, que muy de vez en cuando terminan en cuadros más graves”, le aseguró a El Litoral Carolina Cudós, directora provincial de Epidemiología.




